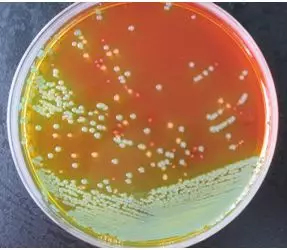
显色平板

食品国家安全标准 4789.5-2012志贺氏菌的检验
发布时间:2019-09-03 浏览次数:4603
志贺氏菌属通称痢疾杆菌,革兰氏阴性杆菌,无鞭毛、无动力。不产生荚膜和芽胞。长约2~3um,宽0.5~0.7um 。分为4个群:A群(痢疾志贺氏菌)、B群(福氏志贺氏菌)、C群(鲍氏志贺氏菌)、D群(宋内氏志贺氏菌)。
1、增菌培养
样品25g加入含新生霉素的250mL志贺氏增菌肉汤中,将此混悬液均质混匀,置于41.5±1℃,16-20h厌氧培养。
Ø 志贺氏菌增菌肉汤
Ø 培养基中除胰蛋白胨、葡萄糖外,加入新生霉素作抑菌剂,并加入少量的吐温80作增溶剂,以帮助样品的充分分散。41℃厌氧培养有助于抑制其它杂菌生长。
2、志贺氏菌的分离
取增菌后志贺氏菌增菌液划线接种在XLD琼脂平板或者MAC琼脂或者志贺显色培养基上,36±1℃培养20h~24h。如果菌落太小或者不典型,则继续培养到48h再观察。


麦康凯琼脂上的51572

XLD琼脂上的51572
显色培养基平板上的志贺氏菌
3、初步生化实验
挑取选择性平板上的2个或2个以上典型菌落,分别接种TSI、半固体和营养琼脂斜面各一管,36±1℃培养20h~24h。
凡是三糖铁琼脂斜面产碱、底层产酸、不产气(福氏志贺氏菌6型可产生少量气体)、不产硫化氢、半固体管中无动力的菌株,挑取用上一步已培养的营养琼脂斜面上生长的菌苔,进行进一步生化和血清学分型。

4、进一步生化实验
将已培养的营养琼脂生长的菌苔,进行生化实验,即β-半乳糖苷酶,尿素,赖氨酸脱羧酶,鸟氨酸脱羧酶以及水杨苷和七叶苷的分解实验。必要时补充做靛基质,甘露醇,棉子糖,甘油,革兰氏染色以及氧化酶实验。对于生化反应不符合的菌株,即使可以与某种血清凝集,但仍不能判定。因某些不活泼的大肠埃希氏菌的生化与志贺氏菌相似,并可以与血清凝集,所以对前面生化符合志贺氏菌属的培养物外加葡萄糖胺、西蒙氏柠檬酸盐、粘液酸盐试验36℃培养24h-48h。
5、血清学鉴定
志贺氏菌没有动力,所以没有鞭毛抗原。志贺菌属主要有菌体O抗原。宋内志贺氏菌没有K抗原。如生化项目符合志贺氏菌的生化特征,而血清阴性的话,可挑取菌苔制成浓菌液,100℃煮沸15min-60min去除K抗原后再检查。
